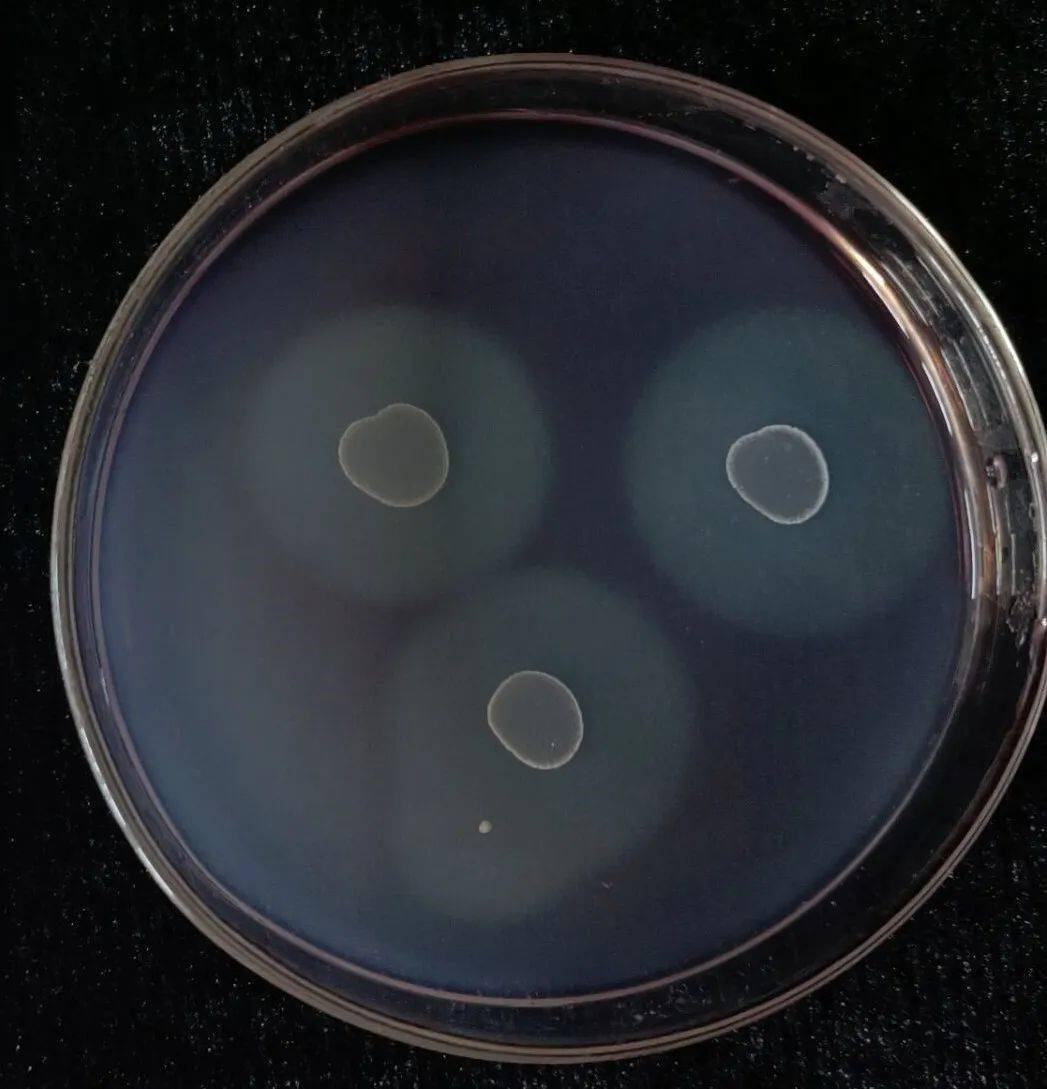
生命·印象:第二十三届"校园之春"文化节之生物文化摄影作品展演决赛

透明圈微生物

科研人-12题库
图片尺寸273x185
抑菌圈 高清晰成像
图片尺寸400x400
丁香园论坛 - 专业医生社区,医学,药学,生命科学,科研学术交流
图片尺寸2816x2112
食品微生物检测 - 食品论坛 - powered by discuz!
图片尺寸329x305
透明体生物
图片尺寸605x746
丁香园论坛 - 专业医生社区,医学,药学,生命科学,科研学术交流
图片尺寸2816x2112
标准说金葡菌在bp上一般有浑浊带和透明圈,怎么看啊?谢谢!
图片尺寸3072x2304
枯草芽孢杆菌淀粉水解圈,蛋白水解圈适应能力强:芽孢杆菌在水体中起
图片尺寸515x237
透明的,里面有一圈圈的,是不是虫卵啊?
图片尺寸1442x786
医学生必看微生物实验报告二药敏试验
图片尺寸1080x1440
本发明属于微生物技术领域:,具体涉及一种解钾菌paraburkholderiasp.
图片尺寸1000x506
青霉菌周围出现了一圈透明带拥有多年研究溶菌酶经验的弗莱明马上意识
图片尺寸400x362
这是平板计数琼脂培养基做的菌落培养,36℃,48小时.
图片尺寸2448x3264
一般筛菌的步骤 - 微生物 - 小木虫 - 学术 科研 互动社区
图片尺寸413x416
生命·印象:第二十三届"校园之春"文化节之生物文化摄影作品展演决赛
图片尺寸1047x1089
产纤维素酶的透明圈该怎么观察需要洗脱吗
图片尺寸750x562
透明的,里面有一圈圈的,是不是虫卵啊?
图片尺寸2219x1035
图2 菌株在 cmc-刚果红培养基上的透明圈表1 两轮复筛获得的突变株在
图片尺寸426x419
本专利技术属于微生物
图片尺寸968x963
由于在土豆汁中含有淀粉类物质,会使能够产生淀粉酶的微生物出现假
图片尺寸284x292